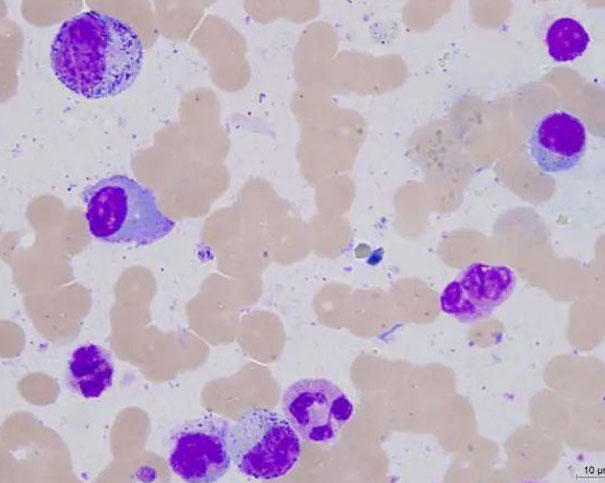
现代医学如何应对浆细胞疾病:解读症状与探索治疗新策略

前沿科普助力疾病恢复,疾病知识改变健康意识

贫血与再障:一字之差的巨大不同!说清关联、讲透应对
当出现面色苍白、时常感到头晕乏力,并被诊断为“贫血”时,很多人心里难免会咯噔一下:这会不会发展成更严重的疾病,比如“再生障碍性贫血”(再障)?贫血和再障之间,到底有什么联系?又该如何区分与应对?本文将带您厘清概念,走出误区。贫血与再障:本质大不相同首先要明确:贫血是一种.........
详细内容

别忽视血常规的“健康密码”!24小时守护你的免疫巡逻兵
血常规常被称为“健康的晴雨表”,却最容易被忽略。在外周血中,中性粒细胞是白细胞家族中人手最众的成员,约占白细胞总数的50%到70%。它们从骨髓中诞生,作为免疫系统的先头部队,持续在血液中执行巡逻任务。一旦身体遭遇病菌入侵或出现损伤,中性粒细胞便作为最快的应急兵力,一方面传递“.........
详细内容

真性红细胞增多症:不只是红细胞增多,注意这些病情进展!
真性红细胞增多症作为一种慢性骨髓增殖性肿瘤,往往在初期不易察觉,缓慢而隐蔽地显现,给患者带来一系列复杂且多变的健康挑战。从最早出现的皮肤泛红、眼结膜充血,到可能诱发的血栓等严重并发症,其疾病进程就像一场暗流涌动的持久战,考验着患者的身体耐力与心理韧性。然而更值得警惕的是.........
详细内容

认识MPN:它并非单病种,而是一个需要甄别的血液病家族
骨髓增殖性肿瘤(MPN)是一类起源于造血干细胞的克隆性疾患,具有明显的异质性,其主要特征为骨髓中一系或多系血细胞过度增生。常见的MPN类型包括真性红细胞增多症(PV)、原发性血小板增多症(ET)、原发性骨髓纤维化(PMF)以及慢性粒细胞白血病(CML),其中部分ET和PV病例可能进一步发展.........
详细内容
现代医学如何应对浆细胞疾病:解读症状与探索治疗新策略
浆细胞是免疫系统中的关键成分,由骨髓中的B淋巴细胞分化而来。当B细胞遭遇抗原(例如细菌或病毒)刺激后,会转变为浆细胞,其主要功能是合成和释放抗体(即免疫球蛋白),以协助中和病原体并调节免疫应答。正常情况下,外周血中没有浆细胞,而骨髓中的浆细胞比例通常低于2%。浆细胞疾病是指.........
详细内容

人体内简单又复杂的细胞:关于红细胞的重新定义
在血液中,红细胞无疑占据一定的主导地位。每滴血液中都含有数百万个红细胞,这也正是血液呈现红色的原因。事实上,从全身范围来看,红细胞同样是数量最庞大的细胞类型。以一位体重70公斤的成年男性为例,其血液中红细胞的数目可达20–30万亿个,约占人体所有细胞的70%,堪称体内细胞中的“绝.........
详细内容

血液为何总是红色?揭秘血红蛋白与光的奇妙相互作用
为什么血液是红色的?这个看似简单的现象背后,其实藏着一系列精巧的生理机制。下面就带您一探究竟。血液之所以呈现红色,关键在于其中的血红蛋白。它如同身体里的“专职快递员”,在肺部装载氧气后,随着血液流动将氧输送到全身各个组织。那么,血红蛋白又是如何发挥这一作用的呢?从结构上.........
详细内容

当红细胞“变形记”上演:八种异常细胞形态背后的健康警示
红细胞在人体内主要负责运输氧气,维持机体正常代谢。健康的红细胞通常呈双凹圆盘形,直径约7–8微米,具有一定变形能力和较大表面积,使其能在血管中顺畅移动。一旦红细胞形态发生异常,就可能引发多种血液疾病,尤其是溶血性贫血。球形红细胞失去正常的双凹形态,变为小而圆的结构,且缺乏.........
详细内容

血液病患者鼻出血怎么办?牢记预防、冷静与正确止血
鼻出血在血液病患者中较为常见,尤其在血小板偏低的情况下更容易发生。轻微时可能仅表现为涕中带血,按压后很快停止;严重时则可能出现血流不止,血液从鼻腔持续外流或向后流入咽部再从口中吐出,按压难以有效止血,甚至伴随头晕、乏力、胸闷等不适。这种情况不仅影响身体状态,也易引起患者.........
详细内容

探索红细胞的奥秘:维系生命源泉的微小守护者之谜
血细胞主要包括红细胞、白细胞和血小板三大类。其中,红细胞,也称为红血球,外形呈双凹圆盘状。它是人体中数量最为庞大的细胞类型,约占总细胞数的80%,我们常用每升血液中的红细胞个数来表示其数量。红细胞由骨髓生成,成熟后进入血液循环执行功能,平均寿命约为80至120天。在健康状态下,.........
详细内容

1、任何有关血液病,都可以扫描二维码或者是搜索“石家庄慈爱中医院”直接与我们在线医护沟通交流;
2、您可以通过微信自带的扫描二维码功能,直接扫描左侧的二维码图像关注我们;
3、扫描二维码,关注微信公众号,可享受最新活动优惠。